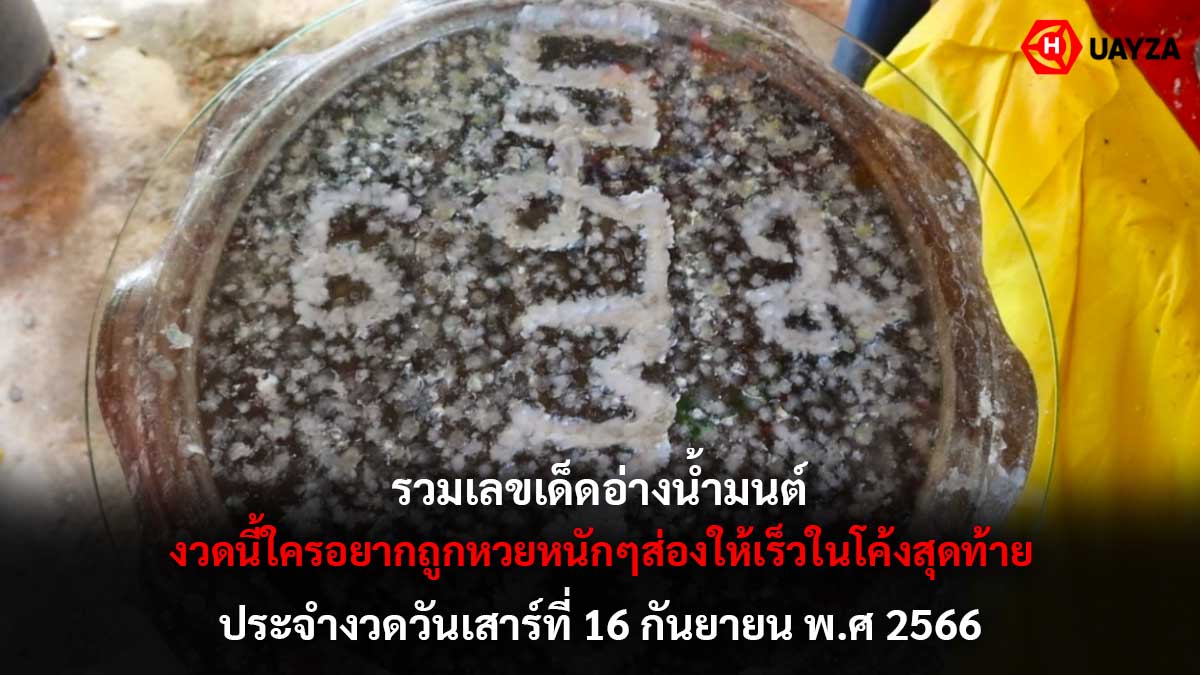

รวมเลขเด็ดอ่างน้ำมนต์ 16 9 66 งวดนี้ใครอยากถูกหวยหนักๆส่องให้เร็วในโค้งสุดท้ายก่อนที่หวยไทยงวดนี้งวดวันเสาร์ที่ 16 เดือนกันยายน 2566 เวลา 16.00 น. และเพื่อไม่ให้เสียเวลทำมาหากิน เสียเวลาออกล่าหา เลขเด็ด เอาไปรวยเอาไปถูกหวยหนักๆ เดี่ยวตามมาดูคามมาเขียนเอาแนวทางรวมเลขเด็ดอ่างน้ำมนต์ประจำงวดวันเสาร์ที่ 16 เดือนกันยายน 2566 ที่เรานำมาให้ได้ดูที่ด้านล่างนี้ได้เลย เพราะเหลือเวลาไม่มากแล้วที่หวยไทยงวดนี้งวด 16 ก.ย. 66 จะออก ว่าแต่มีเลขอะไรบ้างมีเลขที่เราชอบหรือไม่ชอบเดี่ยวตามมาดูไปพร้อมกันไดเลย จะได้รีบไปรวยรีบไปตามแบบจัดหนักจัดเต็มในหวยไทยงวด 16/9/66 นี้
รวมเลขเด็ดอ่างน้ำมนต์มาให้เอาไปรวยหนักๆในหวยไทยงวด 16 กันยายน 2566
กุมารทองเจ้าสัวเฮง 9 ต.โพธิ์แตง อ.บางไทร จ.พระนครศรีอยุธยา
- เลขอ่างน้ำมนต์ เห็นเป็นเลข 3 4 5 6 7 8
- เลขกลุ่มที่ลอยจับกลุ่มเป็นเลข 68 และ 5743
พระมหาจักรพรรดิ ปางเปิดโลก วัดหนองทอง หมู่ 11 ต.บ้านสวน อ.เมือง จ.สุโขทัย
- เลขอ่างน้ำมนต์ เห็นเป็นเลข 6, 9, 0, 8
ไอ้ไข่ วัดโบสถ์ราษฎรศรัทธา ต.บางระกำ อ.โพธิ์ทอง จ.อ่างทอง
- เลขอ่างน้ำมนต์ เห็นเป็นเลข 521-36
ที่มา : thairath.co.th